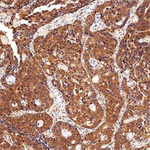
CIP2A Antibody in Immunohistochemistry (Paraffin) (IHC (P))

Search
Invitrogen
CIP2A Monoclonal Antibody (2G10)
{{$productOrderCtrl.translations['antibody.pdp.commerceCard.promotion.promotions']}}
{{$productOrderCtrl.translations['antibody.pdp.commerceCard.promotion.viewpromo']}}
{{$productOrderCtrl.translations['antibody.pdp.commerceCard.promotion.promocode']}}: {{promo.promoCode}} {{promo.promoTitle}} {{promo.promoDescription}}. {{$productOrderCtrl.translations['antibody.pdp.commerceCard.promotion.learnmore']}}
图: 1 / 10
CIP2A Antibody (MA1-46001) in ICC/IF

Please note: We are reviewing Western blot images included in the antibody testing data in our catalog, including those provided by third parties. Unless expressly labeled or annotated as “raw-unedited”, Western blot images included in the antibody testing data in our catalog may have been edited, optimized or otherwise adjusted for presentation.
产品信息
MA1-46001
种属反应
已发表种属
宿主/亚型
分类
类型
克隆号
抗原
偶联物
形式
浓度
规格
纯化类型
保存液
内含物
保存条件
运输条件
RRID
产品详细信息
Suggested positive control: Hela whole cell extract, antigen standard for KIAA1524 (transient overexpression lysate).
靶标信息
Inhibition of protein phosphatase 2A (PP2A) activity has been identified as a prerequisite for the transformation of human cells. The protein, designated Cancerous Inhibitor of PP2A (CIP2A), interacts directly with the oncogenic transcription factor c-Myc, inhibits PP2A activity toward c-Myc serine 62 (S62), and thereby prevents c-Myc proteolytic degradation. In addition to its function in c-Myc stabilization, CIP2A promotes anchorage-independent cell growth and in vivo tumor formation. The oncogenic activity of CIP2A is demonstrated by transformation of human cells by overexpression of CIP2A. Importantly, CIP2A is overexpressed in two common human malignancies, head and neck squamous cell carcinoma (HNSCC) and colon cancer.
仅用于科研。不用于诊断过程。未经明确授权不得转售。
生物信息学
蛋白别名: Cancerous inhibitor of PP2A; p90 autoantigen; p90 autoantigen homolog; Protein CIP2A; similar to RIKEN cDNA C330027C09
基因别名: AA408511; AU018569; CIP2A; KIAA1524
UniProt ID: (Mouse) Q8BWY9
Entrez Gene ID: (Mouse) 224171, (Rat) 360711




